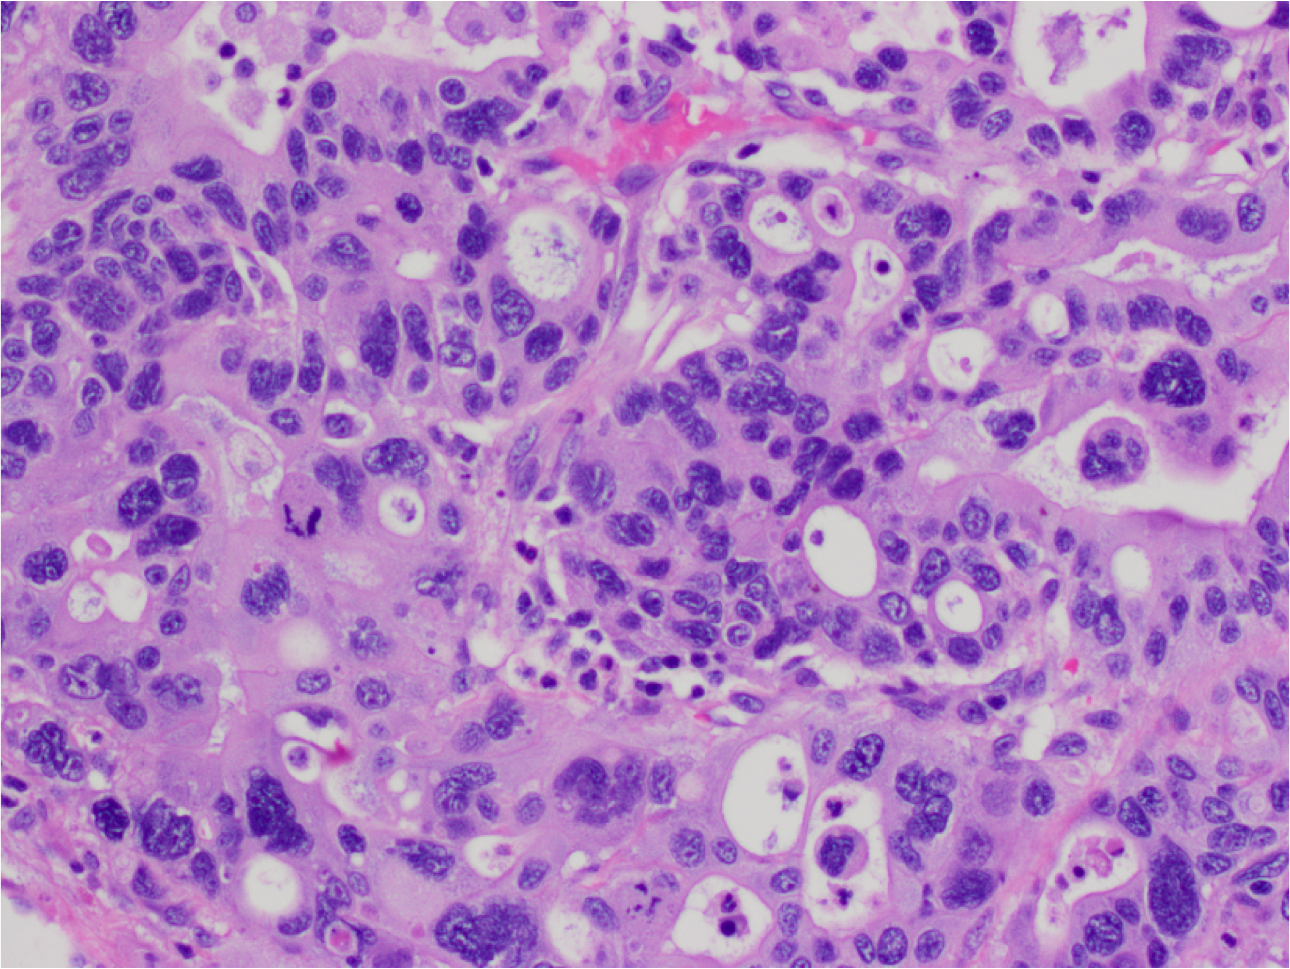
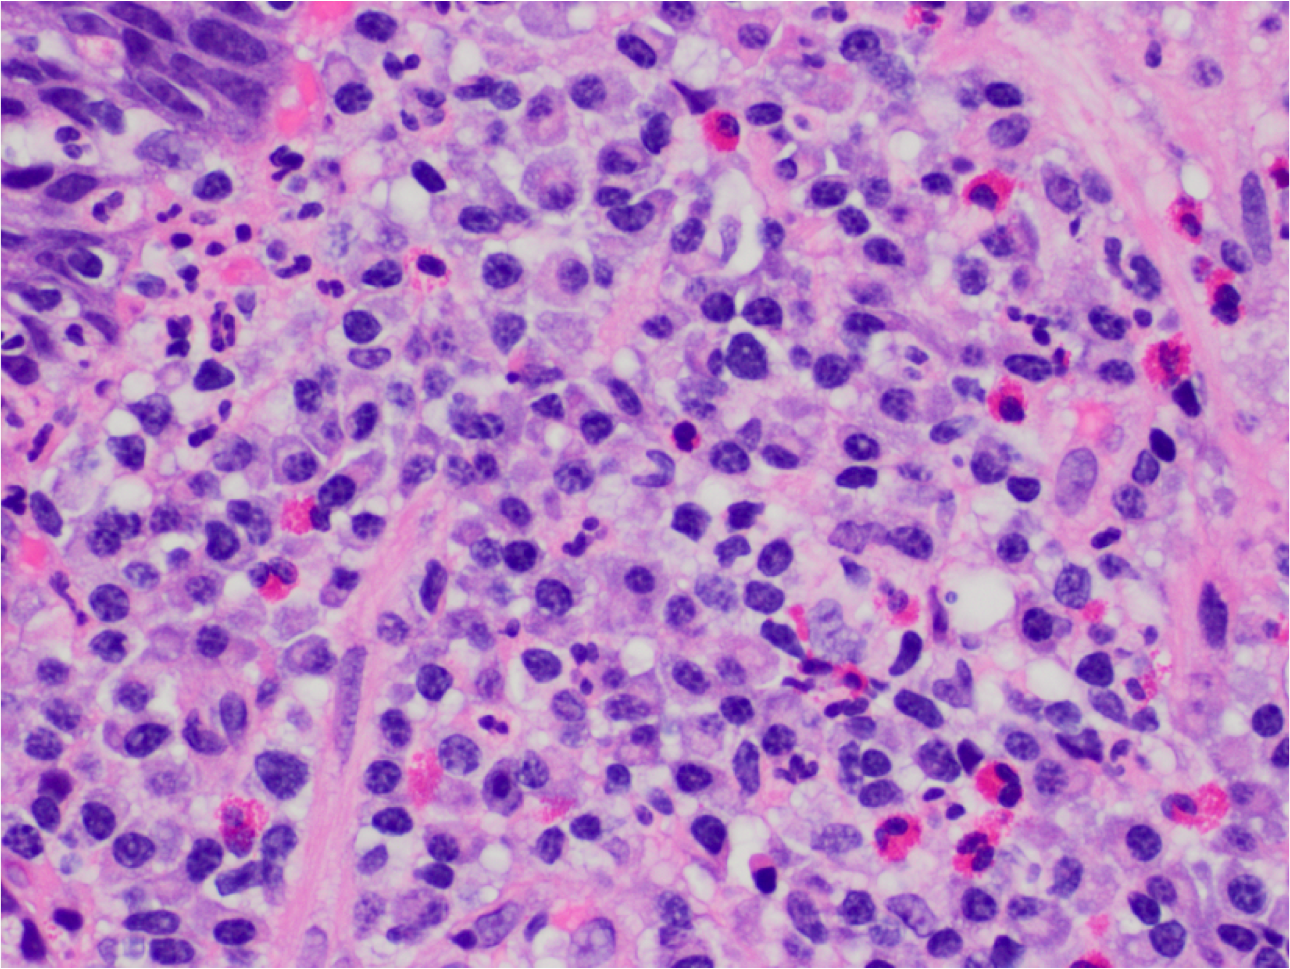
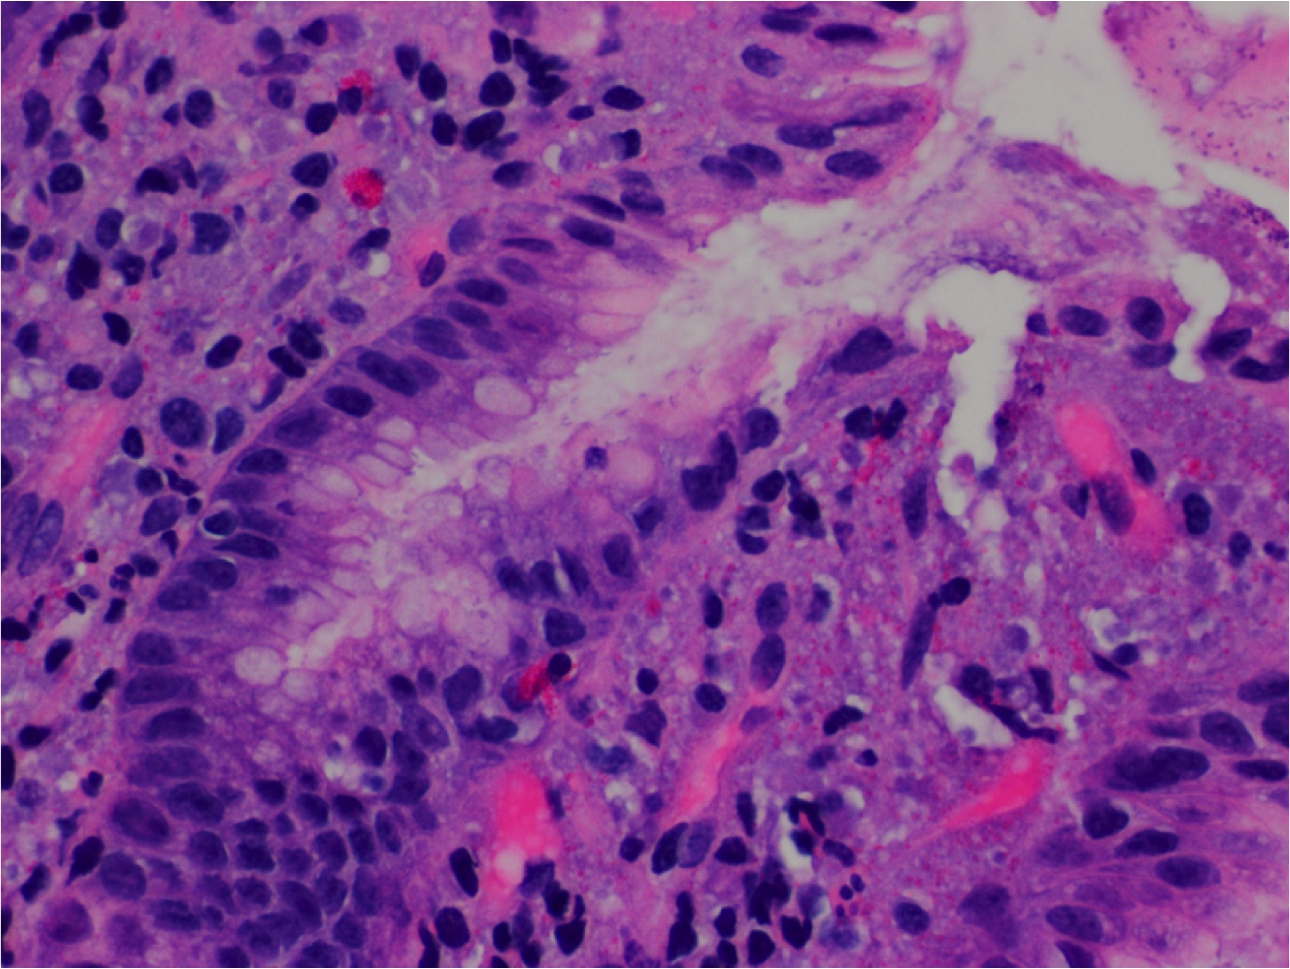
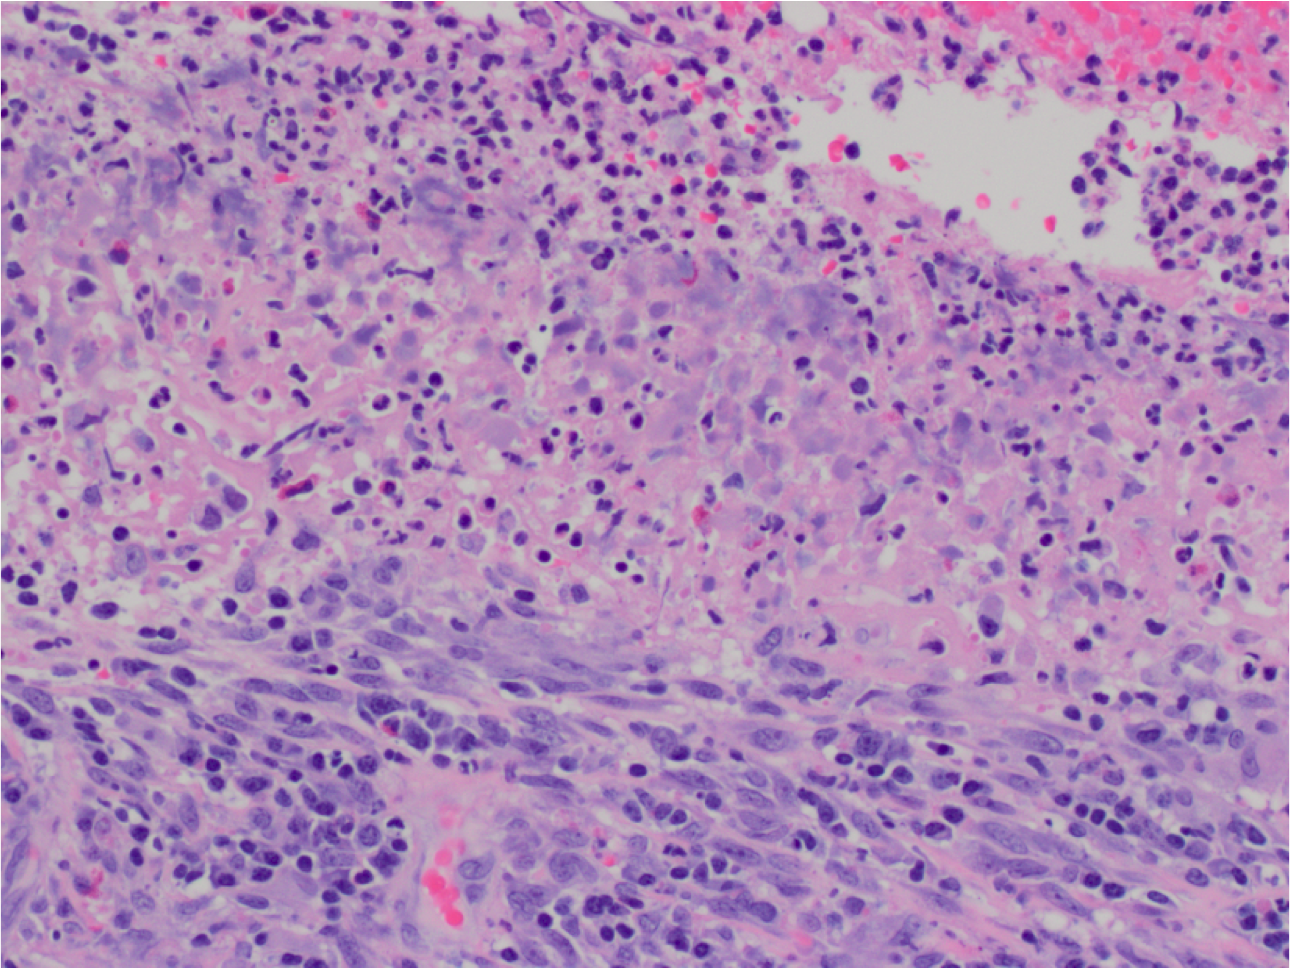
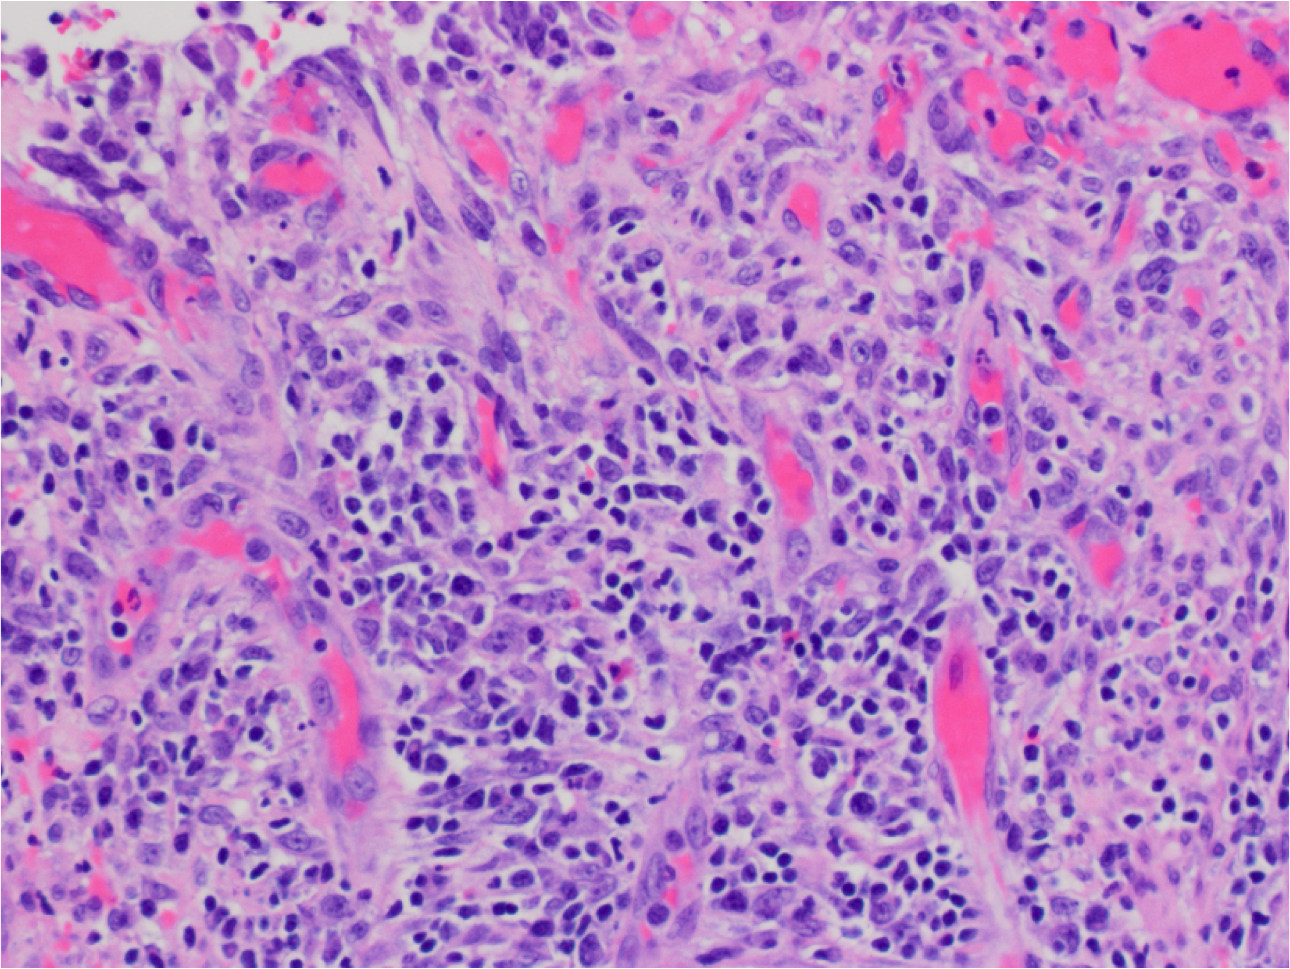

What is this?

Barrett Esophagus, negative for dysplasia.
GEjunction with columnar mucosa of the cardia-type.
What’s this? What’s notable?

Barrett Esophagus.
Gastro-esophageal junction with columnar mucosa of intestinal type (intestinal metaplasia).
Goblet cells are present – note cells with large droplets of grey/blue mucin.
Also note maturation (increasing N:C ratio) of intestinalized epithelium towards the luminal surface of the crypts.
What’s this? notable features?

Barrett’s Esop with high-grade dysplasia and adenocarcinoma.
Intestinalised mucosa with villous architecture, nuclear enlargement and no maturation.
What’s this? Notable?

Adenocarcinoma
Haphazard arrangement, confluence and infiltrative growth of glandular structures
What’s this? Notable?
Adenocarcinoma.
Cribriforming, nuclear pleiomorphism and hyperchromasia, atypical mitoses (middle left).
What’s this?

H Pylori Chronic gastritis.
Dense mononuclear cell infiltrate consisting of plasma cells and lymphocytes is seen in the lamina propria of the antral mucosa.
What’s this?
H Pylori infection
High power view showing lymphocytes, plasma cells and admixture of eosinophils. Presence of neutrophils (small segmented nuclei in the upper left) indicates active inflammation which is very characteristic of H pylori infection.
What’s this?
H. pylori bacteria (short seagull-like structures in the pit lumen) may be seen sometimes on routine staining.
What’s this?

Reactive Gastropathy.
Note corkscrew pits, depleted mucin in the superficial and pit epithelium.
Prominent lamina propria with dilated capillaries and few or no inflammatory cells.
What’s this?

Gastric Ulcer
Mucosal denudation (left) with fibrinopurilent exudate (top), necrosis, and underlying granulation tissue.
What’s this?
Gastric Ulcer
High power view of fibrinopurilent exudate (top), necrosis (middle) and superficial layers of granulation tissue (bottom).
What’s this?
Gastric Ulcer
Underlying granulation tissue -repetitive pattern of capillaries containing RBCs, fibroblasts (top) and inflammatory cell infiltrate (middle and bottom)
What’s this?

Chronic Gastritis
Chronic gastritis in the background mucosa (likely caused by H. pylori) .
What’s this?

Gastric adenocarcinoma
Infiltrative growth of complex glands, which may contain pink necrotic debri (as in this case). Compare to normal crypts on the right.
What’s this?

Gastric Adenocarcinoma.
High power view of malignant glands. Note irregular shape and complexity of the glands with abortive lumina, necrotic debri, nuclear enlargement and mild nuclear pleiomorphism
What’s this?

Peptic Duodenitis
Gastric metaplasia of the superficial epithelium (top and right, note gastric-type mucin in the cells). Compare to the intestinal epithelium with goblet cells on the left.
What’s this?

Peptic Duodenitis.
Active inflammation (neutrophils in the lamina propria, middle).
What’s this?

Celiac Disease
- Total villous blunting and crypt expansion.
- Increased number of lymphocytes in the superficial epithelium.
- Increased density of the lymphocytes and plasma cells in the lamina propria.
What’s this?

Celiac Disease
Increased intraepithelial lymphocytes (more than 20 per 100 epithelial cells, usually no need to count) in the superficial epithelium partially overlapping with the nuclei of the epithelial cells. Lymphocytic nuclei have dark-blue chromatin and are more round.


